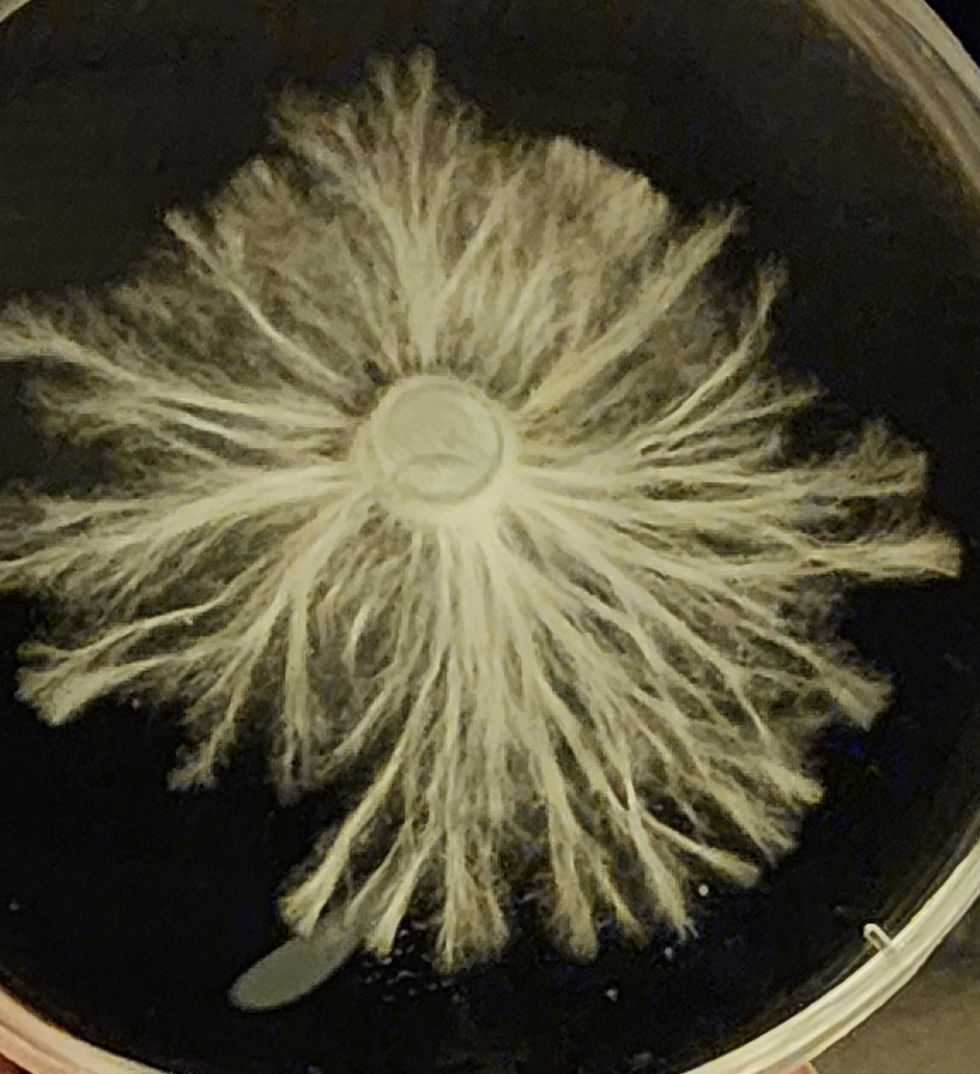
20240801_201948

top of page
My Melted Vision
Welcome to Melted Minds Mycology! Founded in 2024 with a passion for excellence, I am dedicated to providing mycologists with the cleanest genetics available. Each batch is produced in a sterile environment to guarantee the highest quality for your research. As a one-man operation, I take pride in meticulously crafting and testing every product to ensure your success.
Maria Sabina
"The ninos santos (Psilocybe Mexicana) heal. they lower fevers, cure colds, and give freedom from toothaches. They pull the evil spirits out of the body or free the spirit of the sick."

Terence Mckenna
"Life lived in the absence of the psychedelic experience, that primordial shamanism is based on life trivialized, life denied, life enslaved to the ego

bottom of page














